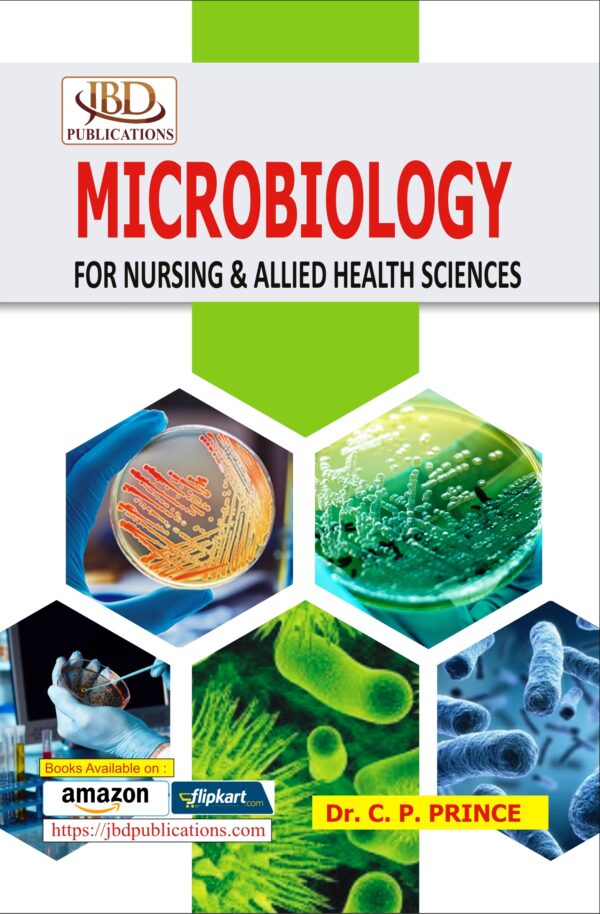
Microbiology for Nursing & Allied Health Sciences

Microbiology for Nursing & Allied Health Sciences
105.00
150.00
Category:
Medical Science
Author:
Dr. C.P. Prince
Edition:
2nd
Language:
English
Publish Year:
2023
Publisher:
JBD Publications
Pages:
96
Type:
ISBN:
9789392330452